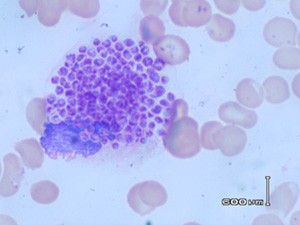

云南组织胞浆菌病与黑热病的鉴别诊断
时间:2006-06-05
浏览量:3285
云南历史上属于黑热病非流行区,组织胞浆菌病病例也较为罕见,由于播散型组织胞浆菌病与黑热病的临床表现和显微镜镜下病原体形态极其相似,我省卫生工作人员容易出现两种疾病的误诊误报,如我省2005年网络直报黑热病1例,但经调查核实,属误诊。
1.组织胞浆菌病
是由荚夹膜组织胞浆菌所引起,通过由鸡、禽、土壤等经空气传播,以侵犯网状内皮系统为主的深部真菌病,呼吸道是主要的传染途径,也可通过皮肤粘膜、血行播散和消化道感染,以侵犯网状内皮系统为主。本病呈世界性分布,主要流行于北美。我国1995年在广州发现首例病例,以后相继发现数例,近年来云南亦有多例个案报道,提示云南存在当地感染的散发病例。
组织胞浆菌病临床一般分为肺型和播散型,其中播散型多见于免疫功能低下者,有显著的全身症状如发热、乏力、咳嗽、胸痛、腹痛、消瘦等,多有肝、脾及淋巴结肿大、贫血、白细胞减少,血小板减少等。
2.黑热病
是由杜氏利什曼原虫引起,通过由媒介白蛉叮咬而传播,侵犯网状内皮系统为主,主要病变发生在内脏,又称内脏利什曼病或Kala-azar。少数特殊病例则以皮肤损害或单纯淋巴结肿大为主要症状,分别称皮肤或淋巴结型黑热病。黑热病主要集中在东非、印度次大陆,我国周边的印度、孟加拉国、巴基斯坦和尼泊尔均有流行,印度是严重流行区。我国目前仅在新疆、四川、甘肃、陕西、山西和内蒙古6省(区)43个县(市)出现当地感染的黑热病, 其中,以川北、陇南和新疆喀什的病人最多。云南省历史上为黑热病非流行区,但1995-1998年在景洪市普文镇曾报道3例黑热病病例。
黑热病临床症状主要为长期不规则发热,脾脏呈进行性肿大,肝脏轻度或中度肿大,白细胞计数降低,贫血,血小板减少或有鼻衄及齿龈出血等症状。(黑热病诊断标准见国标GB15986-1995)
3. 鉴别诊断
表1 播散型组织胞浆菌病与黑热病鉴别诊断
依据 | 播散型组织胞浆菌病 | 黑热病 |
流行病学史 | 1、 非黑热病流行区内的居民,或未曾在白蛉季节内(5~9月)进入流行区居住过; 2、 云南存在少量散发病例; | 1、 黑热病流行区内的居民,或在白蛉季节内(5~9月)曾进入流行区居住; 2、 流行区重点为上述6省(区),云南属黑热病非流行区 |
临床表现 | 发热、乏力、咳嗽、胸痛、腹痛、消瘦等,多有肝、脾及淋巴结肿大、贫血、白细胞减少,血小板减少三系减少)等,约25%患者可出现消化道症状如呕吐、腹泻。 | 长期不规则发热,脾脏呈进行性肿大,肝脏轻度或中度肿大,白细胞计数降低,贫血,血小板减少或有鼻衄及齿龈出血等症状。 |
发热热型 | 发热一般为驰张热; | 约1/2~1/3病例呈双峰热型,即1日内有2次体温升高(升降幅度超过 |
免疫球蛋白lgG | 常正常 | 明显升高 |
病原体形态(吉氏染色骨髓片) | 组织胞浆菌多位于吞噬细胞内,少数散在于细胞外, 呈圆形或卵圆形,大小一致,胞浆呈月牙形,红色的胞核位于胞体的一侧,外有淡蓝色染亮圈的孢子形态 ,无动基体(图1、2) | 杜利体多位于吞噬细胞内,少数散在于细胞外,呈圆形或卵圆形,大小不等,虫体胞质呈淡蓝色或深蓝色,内有一个较大的圆形核,呈红色或淡紫色,在虫体的腹面有一个细小杆状的动基体,呈深紫红色。(图3、4、5) |
穿刺物培养 | 接种到SDAI,BHIB,或MLI培养基上可见菌丝和孢子。 | 接种到三恩氏(NNN)培养基内可见利什曼原虫的前鞭毛体 |
免疫学检查 | 组织胞浆菌素皮内试验阳性 | 间接荧光抗体试验等血清学试验阳性反应,rk39黑热病试条阳性。 |
治疗效果 | 锑剂治疗1~2疗程后无效。抗真菌治疗有效。 | 锑剂治疗1~2疗程常有效 |
预后 | 肺型病程短,症状轻,常自愈; 播散型组织胞浆菌病损害为全身性的,病程长,预后较差 | 预后尚可
|
[NextPage]
图1 播散型组织胞浆菌病患者骨髓涂片(光镜下可见巨嗜细胞内圆形或卵圆形芽生孢子)

图2 播散型组织胞浆菌病患者骨髓涂片:光镜下可见散在的卵圆形芽生孢子,
胞浆呈月牙形,红色的胞核位于胞体的一侧,外有淡蓝色染亮圈的孢子形态(吉氏染色,1000×)。

图3 黑热病患者骨髓涂片:光镜下可见巨嗜细胞内圆形或卵圆形利什曼原虫,
轮廓清楚,虫体大小较为均一,核旁有染色较深、呈杆状或点状的动基体。

图4黑热病患者骨髓涂片:光镜下可见散在卵圆形利什曼原虫,轮廓清楚,
胞浆内深染呈橄榄球形状部分为核,核下圆形部分为动基体。

图5:黑热病利什曼原虫无鞭毛体(杜利体)。前鞭毛体















